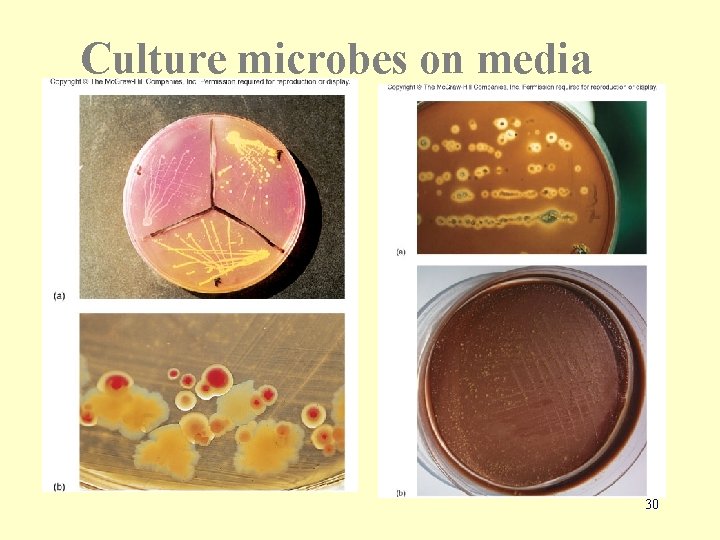
Culture microbes on media 30

How we study microbes Chapter 3 Bacteria were

How we study microbes Chapter 3

Bacteria were the first microorganisms to be studied Small in size 1000 X magnification Most about 200 nm to 1 mm • Robert Hooke • Used the term “cell” • 1665 • Anton van Leeuwenhoek • First to visualize bacteria & protozoa • 1678 • Beginning of the end of “spontaneous generation” 2

Fundamentals of Light Microscopy • Ultimate goal is to obtain information • Two factors affect amount of attainable information • Magnification • Resolution 3

Magnification - How Does a Lens Magnify? Air and glass have different refractive indices, so light refracts (bends) as it passes through a lens. Virtual Image is magnified as once parallel rays now diverge. E Reaches the eye E 4

Pathway of Light in Compound Microscope Virtual Image formed by ocular lens Mistake- Blue and red should be reversed here (page 75) Magnified primary image This lens not for magnificationconcentrates light 5

Magnification Defined as amount of enlargement of specimen Picture of Anton van Leeuwenhoek 1 X 5 X 20 X 100 X • Magnification can be infinite • At some point, no more information can be gathered • Have reached the limiting factor of microscopy - RESOLUTION 6

Resolution • Minimum distance at which two objects can be distinguished (the smaller the number, the better the resolution) • Several factors affect resolution • Wavelength (l) of light • Refractive index (h) of medium between lens and specimen • Distance between lens and specimen • Contrast 7

Resolution = l 2 hsinq l = wavelength of light h = refractive index q = angle between most divergent light ray gathered by lens and the center of the lens Numerical Aperture Mathematical constant that describes the efficiency of a lens 0. 1 in a lowest powered lens (4 X) 1. 25 in the highest power lens (100 X) Higher numerical aperture = Better Resolution 8

l of Light Used Resolution = l 2 N. A. l = wavelength of light 500 nm ----- = 200 nm 2 x 1. 25 • Different colors of light have different l • The shorter the wavelength, the higher the resolution 400 -500 nm is excellent • Thus many light microscopes use filters to select color of 9 light • blue-green l

Refractive Index of Medium Between Specimen and Lens Resolution = l 2 hsinq h = refractive index Light path without oil Light path with oil • Refractive index - ability to bend light • Glass from the slide bends light more than air • Light is bent away from lens as it passes through specimen • Immersion oil has similar refractive index as glass • More light is gathered by the lens, more information 10

Oil Immersion Lens h = 1 for air h = 1. 5 for glass h = 1. 52 immersion oil 11

The Distance Between the Lens and the Specimen • The further the lens from the sample, the more light is lost • The closer the lens, more light gathered • More light means more information and higher resolution • q = angle between most divergent light ray gathered by lens and the center of the lens Lens far from specimen >Q 12 Lens close to specimen

Numerical Aperture Website micro. magnet. fsu. edu/primer/java/nuaperture/ Resolution = Visit this website l 2 hsinq 13

The Parts of a Light Microscope • Two lenses, ocular and objective • Total magnification is obtained by multiplying magnification power of all lenses i. e. Objective lens - 10 X Ocular lens - 40 X Total magnification - 400 X 14

Contrast The maximum intensity difference between the darkest and lightest points in an image • Too much or too little and you lose information • Microscopy has several methods to add contrast 15

Types of Light Microscopy Bright-field Dark-field Phase contrast Fluorescence Differential Interference Contrast (DIC) (Also known as Nemarski Optics) Confocal 16

Bright-Field Microscopy • Condenser creates a bright white background against which to see specimens. • Useful for live, unstained material, preserved & stained material (better). • Disadvantage - cells and organelles within them are often times transparent. • Great for colored materials 17

Dark-Field Microscopy • An opaque disk over middle of light source creates a donut-shaped beam. • The “stop” blocks all light from entering the objective lens except peripheral light that is reflected off the sides of the specimen. • Specimen appears light against a dark background. • Great for observing inclusions in living cells 18

Phase-Contrast • Light is diffracted due to the fact that various intra- and extra - cellular structures have different refractive indexes. • Transforms subtle changes in light waves passing through the specimen into differences in light intensity creating great contrast- background is often grey • Excellent for internal cellular structures. Phase contrast microscopy of a urine specimen. The urine contains epithelial cells, red and white blood cells and baccilli shaped bacteria. 19

3 Views of a Cell • Bright-field • Dark-field • Phase-contrast 20

Fluorescence • A substance fluoresces when it absorbs light at one wavelength, and emits it at another. • Fluorescent stains the cell to produce a bright object on dark background. • Stains can be highly specific by conjugating fluorescent species to antibodies. • Distinguish between live and dead cells. • Diagnosis of infections. 21

Differential Interference Contrast (Nemarski) • Uses prisms in light path to control direction of light • Great for internal structures • Gives a “ 3 -D” effect… 22

Confocal Microscopy • Uses fluorescent stains for contrast. • A laser illuminates a very thin section of the specimen. • Produces a series of very clear images. • Can construct 3 -D images by reconstructing optical sections using a computer. 23

Electron Microscopy page 76 l of electrons smaller than photons Uses electron beam instead of light Uses magnets to focus instead of lenses This results in better resolution – 0. 5 nm • Magnification – 100, 000 to 1, 000 X • • 24

Scanning Electron Microscopy 100, 000 X • Scans and magnifies external surface of specimen producing a 3 -D image • Coat with metal stain • Electrons are deflected off specimen and collected Disadvantage: Cells must be killed 25

Transmission Electron Microscopy • Up to approx. 1, 000 X magnification • Transmitting electrons through very thin sections – (20 -100 nm) • Stained or coated with metals that increase contrast Cyanobacterium 26

Back to Bright Field Light Microscopy Methods to Enhance Contrast • Simple stains – One stain • Differential stains – Use a primary stain and a counterstain to distinguish cell types or parts • Gram stain, acid-fast stain and endospore stain • Special stains – Capsule and flagellar stains 27

28

Staining • Cationic dyes – Basic, with positive charges on the chromophore – Surfaces of microbes are negatively charged and attract basic dyes – positive staining • Anionic dyes – Acidic, with negative charges on the chromophore – negative staining – microbe repels dye & it stains the background 29
Culture microbes on media 30

Media – providing nutrients in the laboratory • Most commonly used: “complex” medium nutrient broth • liquid medium containing beef extract & peptone – nutrient agar • solid media containing beef extract, peptone & agar • Agar is a complex polysaccharide isolated from red algae – solid at room temp, liquifies at boiling (100 o. C), does not resolidify until it cools to 42 o. C – provides framework to hold moisture & nutrients – not digestible for most microbes Opposite of complex medium is simple medium 31

Culture microbes on media Inoculation – Introduction of a sample into a container of media – on agar plates, streaking or spreading Incubation – Under conditions that allow growth Isolation – Separating one species from another Inspection Identification 32

Isolation Technique Pure culture 33

• Selective media - contains one or more agents that inhibit growth of some microbes and encourage growth of the desired microbes 34

Differential media – allows growth of several types of microbes and displays visible differences among desired and undesired microbes 35

Physiological / Biochemical Tests • There are many type of media used to determine – Aerobic / anaerobic growth – Metabolism of carbohydrates – Production of degradative enzymes – Presence metabolic enzymes 36

There are many microbes that scientists do not know how to culture • We know they exist, but we just don’t know how to grow them in the lab • How do we know they exist? – Microscopic evidence – Isolate DNA & RNA • Polymerase chain reaction • Examine the nucleotide sequence – Detect products of respiration • CH 4, CO 2, H 2 S • Many species have been described & named, but never grown in the lab 37

r. RNA Sequence • One of the greatest advancements in classifying organisms • Differences in the nucleotide sequence are used to classify prokaryotes Actually look at the DNA that • 16 S r. RNA sequences codes for the r. RNA • 23 S r. RNA sequences 38


How is this accomplished? Extract DNA from a colony, or from an environmental sample without growing the organism PCR with primers for r. RNA sequences Automated DNA sequencer Compare with known samples in a database 40
- Slides: 40